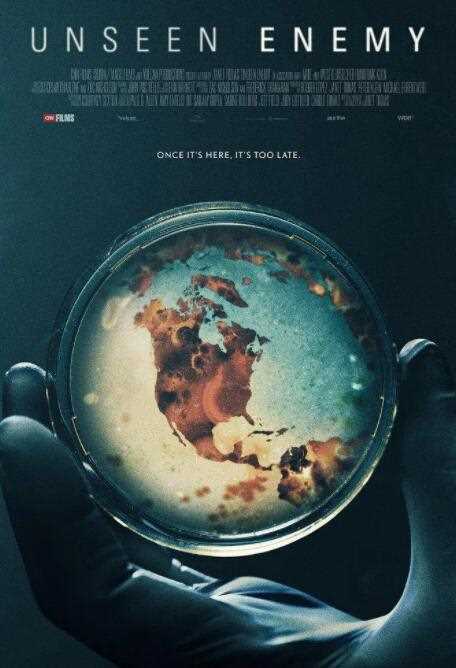
看不见的敌人

莉莉·詹姆斯
超清
Larry,Brilliant,John,Connor,Decontee,Davis,Veronica,Maria,Dos,Santos,Dr.,George,Gao
HD中字
古天乐,张智霖,郑嘉颖,宣萱,黄宗泽,谢天华,张继聪,叶晞月
HD

伊万杰琳·莉莉,布兰登·费尔,寇碧·史莫德斯,钱德拉·韦斯特,科维西·阿梅扬,克里斯·克莱因,麦克·多普德,达斯汀·米利甘,切兰·西蒙斯,亚利桑德罗·雷,保罗·坎贝尔,艾瑞卡·塞拉,莫妮卡·德兰,C.恩斯特·哈斯,杰瑞·瓦塞尔曼,Holly·Eglington,威尔·桑德森,布拉德·西沃森,Michael·Daingerfield,克里斯蒂娜·科普兰,斯特凡·阿尔格里姆,Nicole·McKay,克里斯汀安格斯,Dakota·Morton,Charles·Payne
更新1
郑恺,谢依霖,刘锦航,罗家英,张雨绮,毛毛,王祖蓝,王馨瑶,丁丁,毛俊杰,陈法蓉,程野,甄琪,吴骏超
正片
杰森·斯坦森,霍特·麦克卡兰尼,罗奇·威廉姆斯
HD
花江夏树,三森铃子,木村良平,山口胜平,饭田里穗,齐藤壮马,福田佑亮,村上知子,酒井广大,昴生,亚生,小泉萌香,村上真夏,津田篤宏
正片
暂无
全3集
Sergey,Bezrukov,Aram,Vardevanyan,Nikita,Kologrivyy
更新HD中字
梁碧芝
正片
阿米尔·汗,卡特莉娜·卡芙,阿米达普·巴强,劳埃德·欧文,阿明·阿卜杜勒·奎德,法缇玛·萨那·纱卡
正片
塔丝·潘努,Pavail,Gulati
HD
克里斯·海姆斯沃斯,埃尔莎·帕塔奇,卢克·海姆斯沃斯,利亚姆·海姆斯沃斯
6集全
苏志燮,金允珍,林珍娜,崔广日,黄善熙
HD